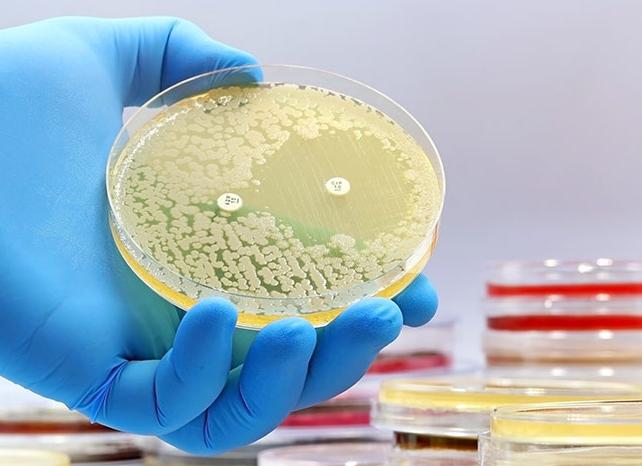
Чем лечить бактерии в моче у женщин

[Чем лечить бактерии в моче у женщин]
[Чем лечить бактерии в моче у женщин]
Бактерии в моче у женщин: причины и лечение
Чаще всего у женщин микробы попадают в мочу по так называемому восходящему пути, поскольку мочеиспускательный канал значительно короче, чем у мужчин. Из-за этого бактериям гораздо проще добраться до мочевого пузыря. Проникают они в уретру из ануса или влагалища, где постоянно присутствуют.
Нисходящий путь подразумевает попадание бактерий в мочевой пузырь из внутренних очагов инфицирования. Чаще всего это почки. Бактерии аналогично переносятся с током крови или лимфы.
Инфицирование возможно и при врачебных манипуляциях. Часто это происходит при введении мочевого катетера.
Бактериурию не всегда сопровождают какие-либо клинические проявления. Тогда говорят о бессимптомной форме заболевания. Она наблюдается в основном у беременных. Несмотря на отсутствие симптомов, патогенная микрофлора может нанести вред здоровью ребенка и привести к родам раньше срока.
В большинстве случаев бактериурию сопровождают частое и дискомфортное мочеиспускание, тупая боль в нижней части живота. На наличие микробов также указывает помутнение и резкий неприятный запах мочи, появление в ней крови или хлопьев.
У женщин из-за специфики анатомического строения очаг инфекции чаще всего находится в уретре или мочевом пузыре. Поэтому повышение температуры тела при бактериурии не происходит. Жар возможен, если инфекция распространилась на почки. Тогда к симптомам прибавляются боль в пояснице и рвота.
При выявлении микробов, особенно если их сразу несколько видов и отсутствуют какие-либо симптомы, рекомендуется сдать анализ повторно для исключения ошибки. Распространены случаи, когда бактериурия обнаруживается по причине небрежного сбора мочи. Микроорганизмы в урине могут появиться при отсутствии гигиены половых органов, загрязнении емкости для сбора биоматериала, длительном времени доставки на исследование.
Для сведения недостоверности результатов анализа к минимуму рекомендуется:
- перед сбором мочи проводить гигиенический туалет половых органов;
- использовать стерильный контейнер для анализов из аптеки и вскрывать его только перед процессом мочеиспускания;
- не затягивать доставку контейнера в лабораторию;
- отложить сдачу анализа на время критических дней.
Если в период менструации отсрочить сдачу мочи не представляется возможным, во время сбора необходимо следить, чтобы кровь не попала в биоматериал. Для этого вводят тампон во влагалище.
При халатном соблюдении вышеуказанных рекомендаций в моче могут присутствовать бактерии, попавшие туда из воздуха или с поверхности кожи. Если все условия выполнены, но микробы обнаружены повторно, назначаются уточняющие исследования. Одно из них – бактериологический посев мочи. Он считается наиболее информативным методом. Бакпосев показывает, какие именно микроорганизмы выявлены и их количество. Это необходимо для определения их чувствительности к антибиотикам и построения эффективной схемы лечения.
Бакпосев информативен, но занимает двое суток. Для экспресс-диагностики бактериурии также проводятся тесты – ГРТ (глюкозно-редукционный), ТТХ (трифенилтетразолия хлорид), нитритный (способ Грисса).
При небольшой численности патогенных микроорганизмов и «безобидном» возбудителе организм способен самостоятельно справиться с проблемой. Такое возможно при высоком иммунитете и в молодом возрасте. Беременным и пожилым женщинам в этом случае все же требуется врачебная помощь.
Универсальной схемы терапии бактериурии не существует. Лечение для каждого конкретного пациента назначается с учетом того, какие именно микроорганизмы в его моче выявлены и какова их чувствительность к антибиотикам. Так, при остром цистите эффективна антибактериальная терапия короткими курсами с приемом таких препаратов, как «Норфлоксацин», «Ципрофлоксацин», «Офлоксацин». Подобное лечение противопоказано женщинам после 65 лет и беременным. Последним запрещен прием антибиотиков группы тетрациклинов и фторхинолонов.
Если бактериурия у беременных протекает бессимптомно, рекомендуются фитопрепараты «Канефрон» или «Цистон», а также народные средства – морс из клюквы или шиповниковый отвар. При наличии симптомов лечение сводится к приему цефалоспоринов: в первые месяцы беременности назначаются «Ампициллин» или «Амоксициллин», а начиная со второго триместра – макролиды, которые наименее токсичны («Эритромицин», «Кларитромицин»). Прием антибиотиков должен контролироваться врачом.
После окончания терапии назначаются повторные анализы мочи. Они необходимы для контроля эффективности проведенного лечения.
Как избавиться от бактерий в моче?
Анализ мочи как средство диагностики
При каких условиях в моче человека появляются бактерии? В норме, когда отсутствуют воспалительные заболевания мочевой сферы и мочевыводящих путей, моча не должна содержать бактерий, лейкоциты, патологические слизевые включения. Если же данные проявления имеют место быть, то это достаточно серьезные симптомы. О том, что у него существуют определенные проблемы, человек. узнает, как правило, после сдачи общего анализа мочи. Однако, следует учитывать и то, что хотя и моча должна быть стерильной, но в нижних отделах мочевыводящих путей (уретра), возможно проникновение естественной микрофлоры (титр присутствия бактерий в анализе мочи с показателями до 10^4 на 1мл является нормой). Также на результаты анализов может влиять недостаточный гигиенический уход за генитальной зоной, стерильность тары, и время хранения материала для анализа. И если в моче обнаружено достаточно большое количество бактерий, но отсутствуют другие признаки инфицирования или воспаления в мочевой системе, рекомендуется произвести анализ повторно, для уточнения диагноза. Если повторный анализ подтвердил заболевание, следует обратиться к врачу. Уролог проведет необходимые исследования, определит вид бактерий и назначит определенную антибиотикотерапию.
Признаки воспаления мочевыводящей системы
Признаки воспаления мочевыводящей системы
- Зуд, жжение,дискомфортные ощущения в уретре, слизистые или гнойные выделения из нее
- Частые позывы к мочеиспусканию
- Болезненное мочеиспускание, боли в конце мочеиспускания и после него.
- Боли внизу живота и в пояснице
- Повышение температуры тела
- Быстрая утомляемость, чувство слабости, вялость, раздражительность
- Эпителиальные хлопья в моче, примесь гноя или крови в моче
!!!Важно!!!
Если наряду с обнаружением бактерий в моче у Вас присутствуют указанные выше симптомы или некоторые из них — немедленно к врачу! Своевременная диагностика и лечение поможет Вам избежать серьезных проблем со здоровьем, таких, например, как хронический гнойный цистит или пиелонефрит.
Пути проникновения бактерий в мочевыводящую систему
Лимфогенный путь проникновения бактерий
- Лимфогенный путь. Данный путь проникновения бактерий существует в случае нахождения внутренних очагов инфекции рядом с органами мочевыводящей системы и почками. При активном размножении бактерий возможно проникновение их в лимфу. Вместе с током лимфы они попадают в мочевой пузырь, а затем и в мочу, где находят благоприятную для развития и размножения среду.
- Восходящий путь. Возможен при проникновении патогенных бактерий извне через уретру, а также при операционных вмешательствах, или медицинских манипуляциях (установка катетера для оттока мочи, цистоскопия и др.)
- Гематогенный путь. Наличие инфекции возможно в любом органе или месте организма. При критических значениях с током крови возможно проникновение патогенной микрофлоры и в мочу.
- Нисходящий путь. Возможен при заболеваниях почек различной этиологии. При возникновении воспаления присоединившаяся патогенная микрофлора с током мочи спускается из пораженного органа в мочевой пузырь.
Профилактика бактериурии
Лучше предотвратить, чем лечить
Чтобы предотвратить появление воспалительных процессов мочевыводящей системы и, как следствие, появление бактерий в моче, необходимо соблюдать комплекс мер, позволяющий контролировать состояние своего здоровья. Тщательно соблюдайте общую гигиену, интимную гигиену и гигиену нижнего белья. Нижнее белье необходимо стирать отдельно от другой, более загрязненной одежды. Не допускайте незащищенных половых актов, если не доверяете своему партнеру в вопросе ЗППП (заболеваний, передающихся половым путем). Многие из инфекций половой сферы поражают и мочевыводящую сферу (гонококк, грибковые инфекции). Будьте осторожны при посещении мест общего пользования (бани, сауны, бассейны)
Следите за общим состоянием своего здоровья, вовремя проходите плановые медицинские осмотры, сдавайте необходимые анализы. При возникновении настораживающих симптомов немедленно обращайтесь к врачу. Как говорят сами врачи, легче предотвратить, чем лечить..
Заболевания, которые характеризуются появлением бактериальной флоры в моче
Мочекаменная болезнь
- Сахарный диабет
- Пиелонефрит
- Уретрит
- Цистит
- Аденома предстательной железы
- Бактериальный сепсис
- Интерстициальный нефрит
- Атеросклеротическая эмболия почечных артерий
- Везикулит
- Нефросклероз
- Мочекаменная болезнь
- Воспаление мочевыводящих путей, почек и мочевого пузыря.
Бактериурия при беременности и в детском возрасте
При беременности возрастает нагрузка на почки
Чаще всего причиной бактериурии беременных является возросшая нагрузка на почки. Ведь теперь им приходится трудиться за двоих. Кроме того, имеет место быть и гормональная перестройка. Также, вследствие давления увеличившейся матки на мочевой пузырь в нем возникают застойные явления, что, в свою очередь, благоприятствует развитию патогенной бактериальной флоры. Такое же давление происходит и на почки, и так перегруженные выведением токсинов. Но вот, анализ мочи произведен, диагноз поставлен, и возникает непосредственный вопрос, как лечить? Многие беременные категорически против антибиотиков, так как они могут навредить будущему малышу. Конечно, если дело касается легкоустраняемых внешних состояний, то можно обойтись и без антибиотиков, достаточно применения местно применяемых антисептических растворов. Но если существует серьёзное состояние, например, тяжелое поражение почек, то антибиотикотерапия необходима по жизненным показателям. Также, нелеченные заболевания урогенитальной сферы могут спровоцировать выкидыш.
Почему он плачет ?
Симптомы и проявления бактериурии в детском возрасте такие же, как и у взрослого человека. Однако, следует учитывать, что дети младшего возраста, а также груднички не в состоянии сообщить вам о болезненных ощущениях, с которыми могут быть связаны самые серьезные заболевания. Поэтому внимательно следите за состоянием здоровья вашего малыша, его гигиеной, питанием. Проведите полное обследование ребенка, чтобы исключить из сферы подозрения такие заболевания как врожденные пороки почек, мочевого пузыря, мочеточников, патологии строения яичек и пахово-мошоночную грыжу (у мальчиков). При появлении тревожных симптомов немедленно обращайтесь к врачу! Симптомы, на которые следует обратить внимание:
- После акта мочеиспускания ребенок громко плачет
- Ребенок постоянно стремится дотронуться до половых органов
- Ребенок, при нормальном потреблении жидкости писает меньше, чем обычно
- Моча выделяется часто, небольшими порциями
- Визуально заметно покраснение, воспаление наружных половых органов
- Понос, озноб, рвота, беспокойное поведение, повышенная температура на фоне малого выделения мочи
Медикаментозное лечение бактериурии
Бисептол — сульфаниламидное средство
Как правило, нефрологи и урологи назначают противомикробные и антибактериальные средства с широким спектром действия. К неосложненным типам инфекций применяются такие средства как Фуразолидон, Нитрофурантоин, Фуразидин. В случае тяжелых бактериальных инфекций показаны такие средства, как сульфаниламиды. К ним относятся такие эффективные лекарственные средства как: Сульфален, Бисептол, Стрептоцид, Сульфапиридазин, Норсульфазол, Сульфадиметоксин.
После применения антибактериальных средств и сульфаниламидов потребуется восстановление естественной бактериальной флоры кишечника, поэтому после окончания курса лечения сульфаниламидами необходимо принимать препараты с пребиотиками, лакто- и бифидобактериями.
Лечение бактериурии народными средствами
Отвар ромашки — противовоспалительное средство
Методы народной медицины могут использоваться лишь как поддерживающая терапия, так как для полноценного лечения они не обладают должным антибактериальным эффектом в отношении патогенной микрофлоры. Как правило, рекомендуется пить отвары ромашки, почек березы, настой коры можжевельника, настой толокнянки, сок листьев петрушки. Кроме этих средств, в аптеке продаются готовые травяные сборы, усиливающие эффект антибиотиков. снимающие воспаление, снижающие проявления симптомов бактериурии. К таким средствам относится. например, Нефрофит.
Как избавиться от бактерий в моче? /видео/
Как приготовить отвар можжевельника Удивительные свойства березовых почек Все о сульфаниламидах Цистит Что означает анализ мочи? Инфекции мочевыводящих путей Бактерии в моче Что можно определить в моче Бактерии под микроскопом Инфекции мочевой системы Как предотвратить инфекции мочевого пузыря Как отличить вирусную инфекцию от бактериальной Лечение инфекции мочевыводящих путей Бактериурия Лейкоцитурия — что нужно о ней знать Вывод:
Появление бактериальной флоры в моче, или, говоря медицинским языком, бактериурия, может быть симптомом серьезных заболеваний. Однако своевременное обращение к врачу и внимательное отношение к своему здоровью, а в необходимых случаях, и своевременное лечение поможет Вам избежать серьезных проблем со здоровьем. Надеемся, что наша статья была максимально информативной и полезной для Вас. Не болейте и будьте здоровы !
Бактерии в моче — Как избавиться от бактерий в моче? Симптомы и лечение
Исследование мочи входит в состав первостепенных видов обследования при разных заболеваниях. Наличие бактерий в анализе мочи является явным признаком воспаления и требует обязательного визита к врачу.
Попытки самостоятельного назначения лекарственных препаратов может оказаться плачевным. Это связано с тем, что бактерии в моче в норме отсутствуют. Их появление связано с развитие патологического процесса, не свойственного здоровому организму.
Немного о важном
Бактерии (микробы) находятся в моче — что это значит? Почему развивается это состояние, опасно ли и как лечить?
Подобные вопросы беспокоят многих, у которых анализ мочи показал бактерии во время очередного обследования.
Бактериурия — это такое состояние, которое сопровождается проявлением в урине патогенных микроорганизмов. Ведь в норме моча – продукт, характеризующийся стерильностью. Появление чужих агентов может означать развитие патологии.
Пути инфекции
Ситуация, при которой выявлены бактерии в анализе мочи, требует обязательного поиска первоисточника. Для начала врач определяет способ проникновения патогенной микрофлоры в пути мочевыводящей системы.
Их бывает несколько:
- Восходящий, при котором бактерия попадает в мочевые пути через мочеиспускательный канал. Если в вашей моче обнаружены бактерии, то заражение произошло в большинстве случаев именно этим путем. Обусловлено данное обстоятельство анатомическими особенностями строения женской мочевыводящей системы. Много других причин данного варианта инфицирования: инструментальные манипуляции в виде катетеризации мочевого пузыря, уретроскопии, цистоскопии, бужирования уретры, трансуретральных оперативных вмешательств.
- Нисходящий, который связан с инфекционными процессами. Часто именно бактерии в больных почках стали основной причиной бактериурии.
- Лимфогенный, когда микроорганизм попадает из очагов инфекции через лимфатические пути. Как правило, данные инфекционные образования располагаются недалеко от органов, относящихся к мочеполовой системе.
- Гематогенный, при котором в анализе мочи бактерии появляются в связи с занесением инфекции с кровяным потоком из очагов, расположенных отдаленно.
Формы патологического процесса. Выделяют несколько форм состояния, при котором присутствуют в моче бактерии.
К ним относятся:
- Истинная форма. Названа так потому, что сопровождается не только попаданием патогенных микроорганизмов в пути мочевыводящей системы, но и их размножением. Последствием этого является сильный воспалительный процесс.
- Ложная форма, при которой бактерии попадают в мочевой пузырь и мочевыводящие пути, однако распространения инфекции не произошло. Последнее может быть связано с двумя причинами: приемом антибактериальных препаратов или сильным иммунитетом.
- Скрытая форма, которую выявляют обычно при прохождении планового осмотра. При этом проявления заражения отсутствуют. Довольно часто выявляют бактерии в анализе мочи у женщин в положении.
Провоцирующие факторы
Анализ мочи на бактерии в норме у здорового человека должен показывать их отсутствие. Причинами выявления патогенной микрофлоры становятся разные обстоятельства.
Чаще всего к ним относятся:
- нарушение правил личной гигиены (часто подвержены дети при отсутствии тщательного контроля со стороны родителей);
- не соблюдение рекомендаций для сбора мочи в качестве материала исследования;
- нарушение стерильности посуды для сбора биологической жидкости;
- нарушение стерильности в лаборатории, где проводилось исследование мочи;
- изменение окружающего температурного режима (переохлаждение или перегревание);
- снижение защитных сил организма при наличии инфекционного процесса (часто у ребенка в силу несовершенства иммунитета);
- повреждение органов мочеполовой системы;
- половая жизнь с разными партнерами без применения презерватива (часто из-за этого появляются бактерии в моче у молодых женщин).
С целью подтверждения диагноза анализ может сдаваться не один раз. Бактериурия обычно сопровождается и другими симптомами. Часто бактерии в моче имеют причины патологического характера. Общий анализ мочи при этом выявляет повышенное содержание лейкоцитов и слизь.
Это требует обязательного обращения к врачу, который назначит адекватное лечение. Ведь инфекция, находящаяся в организме, может затронуть другие системы.
Признаки развития бактериурии
В большинстве случаев бактериурия дает о себе знать наличием определенной симптоматики.
Она включает следующие проявления:
- нарушение процесса мочеиспускания: урежение или учащение;
- развитие диспепсических признаков;
- изменение температуры тела;
- развитие слабости, озноба, головной боли;
- болезненные ощущения в поясничном отделе спины;
- изменение цветовых характеристик мочи, когда урина меняет свой оттенок, запах, появляются различные примеси (кровь, гной);
- выделения из половых путей с резким неприятным запахом;
- болезненные ощущения при мочеиспускании;
- изменение количества выделяемой мочи;
- ситуации непроизвольного мочеиспускания.
Следует отметить, что не всегда бактериальный процесс может означать наличие яркой симптоматики. При развитии бессимптомной бактериурии отсутствует клиника заболевания. Бактерии в исследовании мочи будут находить при проведении планового обследования.
Несколько затруднено выявление специфических признаков у ребенка, особенно 1 месяца жизни. Плач, постоянное беспокойство, поджимание ножек к животу у ребенка часто молодыми родителями путается с обычным расстройством кишечника. Это затрудняет своевременное лечение.
Диагностические мероприятия
1 этап диагностики включает сбор мочи в соответствии с требованиями. Для этого в стерильную посуду собирают третью порцию урины непосредственно перед проведением анализа. Этот анализ имеет разные методы проведения: быстрые и высокочувствительные.
Методы 1 группы часто проводят в экстренных ситуациях. Для проведения второй группы необходимо больше времени, однако их преимущество – в информативности.
Независимо от поставленного диагноза необходимо проведение исследования мочи не менее двух раз. Это позволит наверняка обнаруживать микроорганизмы, получая более точные результаты. Ведь ошибка в исследовании опасна отсутствием лечения или неправильным подбором лекарственных препаратов.
Лечение и особенности
Наличие бактерий в моче требует обязательного врачебного контроля. Только специалист может назначить правильное лечение, исходя из причины патологии. Ведь бактериурия – это всего лишь 1 симптом заболевания.
Поэтому лечение и решение о том, какие методы эффективны, должно быть определено исходя из поставленного диагноза.
1 стандартное направление борьбы с развитием патогенной микрофлоры — курс антибиотиков. Параллельно с ними прописывают препараты, нормализующие здоровую микрофлору.
Третье направление терапии – симптоматическое лечение. Оно заключается в применении не стероидных противовоспалительных препаратов, витаминотерапии, спазмолитиков.
Значение отсутствия лечения
Если обнаружены бактерии в моче, однако человек не принял никаких действий, это опасно развитием осложнений. Негативные последствия могут быть также, когда назначено неправильное лечение.
К распространенным осложнения развития бактериурии являются:
- Развитие почечной недостаточности. Наличие длительного воспалительного процесса приводит к тому, что нарушается гармоничное функционирование почек. Возникают такие признаки отравления организма, как тошнота, часто сопровождающаяся рвотой, развитие слабости, головной боли. Происходит изменение количества выделяемой мочи, вплоть до ее полного отсутствия. Однако назначенное лечение может восстановить функции почек при острой форме заболевания.
- Развитие эклампсии. Особенно опасно при вынашивании ребенка. Характеризуется высокими цифрами кровяного давления. С целью разрешения состояния проводят мероприятия по улучшению оттока жидкости из организма, предупреждению отека мозга, снятию сосудистого спазма.
- Гематурия, которая характеризуется примесями крови в урине. Развивается обычно как следствие сильного инфекционного процесса, повреждения сосудов органов моче выделительной системы. Обильное кровотечение сопровождается развитием анемии.
- Пиелонефрит. Часто развивается как последствие цистита.
- Бесплодие. Может стать осложнением уретрита. Встречается как у мужчин, так и у женщин.
Профилактика патологии
В профилактике любого заболевания можно найти три плюса: предупреждение осложнений, экономия времени на лечение и покупку лекарств, сохранение здоровья.
К профилактическим мероприятиям по предупреждению бактериурии относят:
- использование презерватива во время интимной близости;
- соблюдение личной гигиены;
- правильное и качественное питание;
- своевременное прохождение профилактических осмотров;
- занятия спортом для повышения иммунитета.
Предупреждение бактериурии у ребенка требует тщательного контроля со стороны родителей за соблюдением правил личной гигиены и сдачу мочи с профилактической целью.
Наличие патогенной микрофлоры в моче – явный сигнал о нарушении здоровья. О том, как это лечить, грамотно расскажет только врач. Не следует заниматься самостоятельным подбором лекарственного средства. Этим можно не только навредить себе, но и спровоцировать развитие осложнений.
Похожие статьи
(Пока оценок нет) Загрузка…
Причины появления бактерий в моче, лечение и профилактика
Общий анализ мочи является одним из самых частых лабораторных исследований, проводимых с целью диагностики заболеваний. По результатам изучения урины можно выявить не только уровень сахара, указывающий на возможное появление диабета, но и различных паразитов. К ним относятся бактерии и грибы, которые не должны присутствовать в моче здорового человека. Появление патогенной микрофлоры, в большинстве случаев, указывает на развитие патологического процесса в организме и требует лечения.
Анализ мочи помогает установить наличие бактерий, присутствующих в организме человека
Бактериурия и особенности ее диагностики
Нормальным показателем здоровых почек и мочевыводящих путей является стерильная урина. Состояние, при котором в ней обнаруживаются бактерии, называется бактериурией. Появление патогенных микроорганизмов в анализах указывает на развитие воспалительного процесса в выделительной системе.
Выявление микробов осуществляется с помощью микроскопического исследования образцов мочи. Концентрация клеток микроорганизмов в титрах в пределах 104-105 КОЕ в 1 мл материала говорит о бактериальной загрязненности урины. В процессе исследования могут быть обнаружены различные микроорганизмы: кишечные палочки, стафилококки, стрептококки, протеи, синегнойные палочки.
Бактериурия относится к симптомам поражения не только почек, но и мочевого пузыря, предстательной железы и семенных пузырьков. Она развивается при различных обстоятельствах:
- у больных, перенесших инфекционные заболевания;
- при длительных запорах;
- у людей с проблемами в толстом кишечнике и трещинами в заднем проходе;
- при наличии очагов воспаления в других органах, откуда паразиты с помощью лимфы попадают в почки.
Для детей и женщин диагностика бактерий в моче является особенно частым явлением. Ребенку не составляет труда застудить мочевой пузырь: достаточно намочить ноги или пройтись по холодному полу без носков. Женщины чаще мужчин страдают от воспалительных процессов в почках в связи с особенностями анатомического строения. Они связаны с коротким уретральным каналом, который легко и быстро преодолевается бактериями.
На наличие воспалительных заболеваний в организме человека, указывает наличие бактерий, которые обнаруживаются в анализе мочи
Формы развития бактериурии и пути инфекции
Назначение лечения при обнаружении бактерий в моче требует обязательного поиска первоисточника воспаления. Для этого врачу необходимо узнать, каким образом микроорганизмы оказались в мочевыводящих путях. Существует несколько способов проникновения микробов в соответствующие органы, а затем в мочу:
- Восходящий, при котором движение инфекции наблюдается из уретры в почки и мочевой пузырь. Заражение может произойти во время инструментальных исследований, например, катетеризации, бужирования.
- Нисходящий – бактерии попадают в уретру из очагов воспаления в почках и предстательной железе, а также задней части мочеиспускательного канала.
- Лимфогенный, когда патогены по лимфатической системе перемещаются из половых органов и кишечника. В последнем случае дополнительно диагностируется энтероколит и проктит.
- Гематогенный, при котором бактерии появляются в результате инфекционных заболеваний: брюшном тифе, гриппе, бруцеллезе.
Различают три основных формы развития бактериурии: истинную, ложную и скрытую. Истинное заболевание проявляется, когда микроорганизмы попадают в мочевыводящие пути, размножаются и провоцируют развитие сильного воспалительного процесса. Ложная бактериурия диагностируется при обнаружении остаточных микробов в моче. В этом случае распространение инфекции не произошло благодаря приему антибиотиков или реакции иммунитета. Скрытая форма выявляется при прохождении плановых осмотров, характеризуется отсутствием заражения. Очень часто встречается у беременных женщин.
При воспалительном процессе в почках и мочевом пузыре инфекция может попасть в мочеточник, а соответственно и в мочу
Основные факторы, провоцирующие заболевание
При обнаружении бактерий в моче возникает закономерный вопрос, что является причиной развития патогенного процесса. К одному из возможных объяснений относится несоблюдение правил интимной гигиены, особенно у детей. Среди других обстоятельств выделяются различные технические ошибки. Например, неправильный сбор мочи для анализа или нарушение технологии исследования в лаборатории.
Другие причины появления бактерий в урине бывают следующие:
- ослабление иммунитета, в частности, из-за охлаждения или перегрева;
- повреждение органов мочеполовой системы;
- беспорядочная сексуальная жизнь;
- различные заболевания почек, например, пиелонефрит, цистит, нефрит;
- воспаления в кишечнике, к которым относятся проктиты, геморрой, паратиф;
- сахарный диабет;
- заражение крови бактериального происхождения.
Для подтверждения диагноза очень часто приходится сдавать анализ несколько раз. Помимо бактерий в моче может быть повышенное содержание лейкоцитов, которое указывает на пиелонефрит, цистит и мочекаменную болезнь. Появление микробов в урине также может сопровождаться увеличением количества белковых соединений, что указывает на повреждение почек.
В анализе мочи могут быть обнаружены различные бактерии, которые являются причиной воспалительных процессов. К ним относятся:
Основные причины появления бактерий в моче: пиелонефрит и цистит, уретрит и камни в почках
- Escherichia coli, которая в норме обитает в нижних отделах кишечника. В мочевыводящие пути попадает при выделении кала, частицы которого могут оставаться на половых органах. Впоследствии бактерия перемещается в уретру и мочевой пузырь.
- Enterococcus faecalis в норме присутствуют в ЖКТ всех людей и принимают участие в процессах переваривания пищи. В мочевыделительную систему попадают через кал, а также при поражениях кожных покровов в области таза.
- Клебсиелла входит в состав патогенной микрофлоры кишечника. Миграция в почки и мочевой пузырь возможна у людей с ослабленным иммунитетом. Источником заражения является сам человек, не соблюдающей правила личной гигиены.
Симптомы проявления
В связи с тем, что заболевание тесно связано с другими воспалительными процессами, симптомы выделяют многочисленные. В большинстве случае бактериурия проявляется в виде:
- нарушения мочеиспускания, выраженного в частых позывах к опорожнению мочевого пузыря;
- повышения или понижения температуры тела;
- появления слабости, озноба, головных болей;
- болей в области почек и поясничного отдела позвоночника;
- изменения цвета и консистенции мочи;
- мочеиспускания с резкими болями и жжением;
- появления выделений из половых путей с неприятным запахом.
Дети, так же как и взрослые подвержены воздействию бактерий. Причем вероятность проникновения патогенов в мочевыводящую систему довольно высокая в связи со слабым иммунитетом. Особенно это касается малышей грудного возраста. При заражении патогенами дети становятся раздражительными, у них нарушается питание, может повышаться температура тела. Перечисленные симптомы характерны для воспалительных процессов в целом, поэтому не всегда удается связать их появление с бактериурией.
При бактериурии мочевыводящих органов наблюдаются такие симптомы как: проблемы с мочеотделением, боль в пояснице, выделения разного характера
Принято считать, что бессимптомное протекание болезни в сочетании с небольшим количеством особей паразита, может самостоятельно разрешиться. Однако данная терапевтическая стратегия не относится к беременным женщинам, пожилым людям и лицам с пониженным иммунитетом.
Диагностика
Основным исследованием, выявляющим появление микроорганизмов, является общий анализ мочи. Для того чтобы результаты изучения урины были максимально достоверны, необходимо соблюдать правила сбора материала. Выделяют основные требования при подготовке к сдаче анализа:
- моча предоставляется в стерильном контейнере, который приобретается в аптеке;
- сбор материала проводится с утра, причем необходима средняя порция урины, скопившейся за ночь;
- накануне вечером не следует принимать лекарственные препараты, алкоголь и употреблять в пищу окрашивающие продукты (свекла, морковь);
- моча собирается строго натощак;
- перед сдачей анализа важно не подвергать организм переохлаждению или перегреву.
Исследование материала может проводиться быстрым или высокочувствительным способом. В последнем случае требуется больше времени, но точность результатов значительно повышается. Независимо от скорости изучения мочи, рекомендуется сдавать анализ минимум два раза, чтобы избежать возможных ошибок.
После обнаружения микробов в моче необходимо определить, какие виды патогена поселились в мочевыводящих путях. Для этого применяется бактериальный посев мочи на питательную среду. Анализ проводится достаточно быстро, результаты можно получить уже через три дня.
Для определения бактерий в моче, назначается общий анализ мочи, собранный в утреннее время
Помимо общего анализа мочи могут использоваться экспресс-тесты, которые напоминают тесты на беременность. Они оценивают уровень глюкозы в урине. В случае ее полного отсутствия можно диагностировать большое количество бактерий в материале.
Лечение и возможные осложнения заболевания
Основным методом лечения является антибиотикотерапия. Врачами достаточно часто назначаются фторхинолоны, к которым относятся левофлоксацин, норфлоксацин, офлоксацин, пефлоксацин. Однако отмечается, что бактерия Escherichia coli не всегда поддается воздействию препарата.
Для детей и беременных женщин, которым противопоказаны фторхинолоны, применяются амоксициллин и цефалоспорины II–III поколений. Преимущество этих препаратов заключается в высокой активности по отношению к E. coli. Кроме того, они безвредны для организма и могут применяться в первом триместре беременности.
Курс лечения зависит от особенностей протекания бактериурии. Как правило, если отсутствуют факторы риска, терапия назначается на 3-5 дней. При острой инфекции верхних мочевыводящих путей длительность курса увеличивается до 14 дней.
При отсутствии грамотного лечения возможно развитие осложнений, опасных для здоровья человека. Среди них выделяются:
- почечная недостаточности, которая сопровождается признаками отравления, изменением количества выделяемой мочи вплоть до полного ее отсутствия;
- формирование эклампсии, выражающееся сильным повышением кровяного давления;
- гематурия, характеризующаяся появлением примесей крови в моче;
- пиелонефрит, являющийся следствием развития цистита;
- бесплодие как у мужчин, так и у женщин.
Лечение бактериурии предполагает использование антибиотиков, имеющих широкий спектр действия
Профилактические меры
Предупреждение развития заболевания имеет три основных преимущества: отсутствие осложнений, экономия средств на лекарствах и сохранение здоровья. К профилактическим мероприятиям, рекомендованным для исключения появления бактериурии, относятся:
- использование барьерной защиты при половых контактах;
- соблюдение личной гигиены, особенно в интимной области;
- поддержание здорового образа жизни и правильного питания;
- своевременное прохождение диспансеризации;
- укрепляющие меры для повышения иммунитета.
В отношении детей необходим тщательный контроль за состоянием их здоровья, а также формирование полезных привычек. Важно вовремя сдавать анализ мочи на проверку и не игнорировать рекомендации педиатров.
Причины появления бактерий в моче, лечение и профилактикаСсылка на основную публикацию